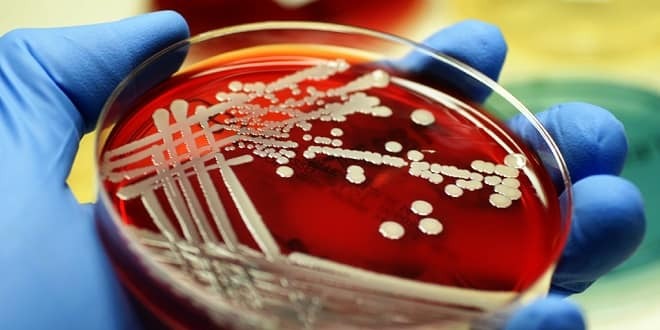

Burc Karakas · 18 Kasım 2021

Mikrobiyoloji, çıplak gözle görülemeyecek kadar küçük olan tüm canlı organizmaların incelenmesidir. Bu, topluca 'mikroplar' olarak bilinen bakteri, arkea, virüsler, mantarlar, prionlar, protozoa ve algleri içerir. Mikrobiyoloji uzmanı ise, bu mikropların ortaya çıkışından yok oluşuna kadar geçen süreci inceleyen bilim insanıdır.
Mikrobiyoloji araştırmaları, yaşanabilir bir dünyadaki sağlıklı habitatlar için gıda, su ve enerji güvenliğini sağlamak gibi mevcut küresel istek ve zorlukların birçoğunu karşılamak suretiyle varlığını devam ettirir. Mikrobiyoloji araştırması aynı zamanda 'Dünya'da yaşam ne kadar çeşitlidir?' ve 'Yaşam, evrenin bir başka yerinde de var mı? gibi sorulara da cevap aramaktadır.
Mikrobiyoloji Uzmanı Olmak İçin Hangi Eğitimi Almak Gerekir?
Mikrobiyoloji uzmanı olmak isteyen kişilerin öncelikle üniversitelerin, tıp, biyoloji, kimya ve veterinerlik gibi bölümlerini bitirmesi gerekir. Mezun olduktan sonra da TUS’tan (Tıpta Uzmanlık Eğitimi Giriş Sınavı) yeterli puanı alıp mikrobiyoloji alanında ihtisas eğitimi almalıdır. Tüm bu eğitim sürecinden sonra mikrobiyoloji uzmanı unvanına ulaşan kişiler, tıp, gıda ya da ilaç gibi farklı sektörlerde de çalışabilir.
Aranan Nitelikler
Mikrobiyoloji Uzmanının Görev Tanımı Nedir?
Mikrobiyoloji uzmanları, genellikle laboratuvar ortamında çalışır ve gelen örnekleri inceler. Bu nedenle ilk olarak mikrobiyoloji uzmanlarının, iş sağlığı ve güvenliğine dikkat ederek çalışması beklenir. Bunun dışında mikrobiyoloji uzmanlarının görev ve sorumlulukları şöyle sıralanır;
Mikrobiyologlar, birçok önemli küresel soruyu mikropları anlayarak yanıtlamayı amaçlamaktadır. Üniversitelerdeki laboratuarlardan, araştırma enstitülerinden ve sanayi şirketlerinden saha çalışmasında mikropların araştırılmasına kadar birçok yerde çalışırlar.
Sağlık Hizmetlerinde Mikrobiyologlar
Mikrobiyologlar mikropların neden olduğu problemleri çözmeden veya yeteneklerinden faydalanmadan önce mikropların nasıl çalıştığını bulmak zorundadırlar. Daha sonra bu bilgiyi hastalığı önlemek veya tedavi etmek, yeni teknolojiler geliştirmek ve genel olarak hayatımızı iyileştirmek için kullanabilirler.
Mikrobiyologlar, hastalıkları tedavi etmemize yardımcı olmak için gereklidir. Birçoğu hastanelerde ve laboratuarlarda biyomedikal bilim adamları olarak; enfeksiyonları teşhis etmek, tedavileri izlemek veya hastalık salgınlarını izlemek için vücut dokusu, kan ve sıvı örneklerini test etmek amacıyla çalışırlar.
Çevre ve iklim değişikliği
Mikroplar, kirlenmiş toprakları ve petrol döküntülerini, biyolojik iyileştirme adı verilen ekolojik olarak önemli bir süreçte temizlemek için kullanılabilir.
Bazı mikrobiyologlar, mikropların okyanustan, tuz göllerine ve Kutup Bölgelerine kadar farklı habitatlardaki diğer canlılarla birlikte nasıl yaşadığını inceliyorlar. Bazıları kirliliği tespit etmek için erken uyarı sensörleri geliştirerek, endüstriyel atıkları işlemek için mikroplar kullanıyor. Diğerleri, mikropların atmosferik koşulları ve iklimi nasıl etkilediğine bakarak dünya çapında iklim değişikliği araştırmasına katkıda bulunuyor.
Tarım ve Gıda Güvenliği

Mikroplar birçok gıdanın üretimi için gereklidir. Mikroplardan peynir, ekmek ve yoğurt hatta çikolata ve salam yapmak için faydalanabiliyoruz.
Mikroplar ekinlerde ve çiftlik hayvanlarında hastalığa neden olabilirken, ekin verimini artırmak için zararlıları ve yabani otları kontrol etmeye de yardımcı olabilirler.
Mikrobiyologlar, mikropların topraktaki hayati rolünü araştırır. Bazıları bitki zararlarına ve hastalıklarına odaklanır, onları kontrol etmek için yollar geliştirir, hatta böcek zararlılarını ve yabani otları kontrol etmek için mikroplar kullanır.
Hayalinizdeki üniversiteyi bulalım